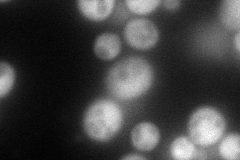
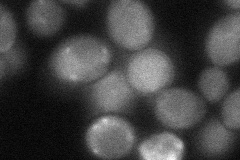
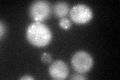

View description
Lsm (Like Sm) protein; forms heteroheptameric complex (with Lsm2p, Lsm3p, Lsm4p, Lsm5p, Lsm6p, and Lsm7p) involved in degradation of cytoplasmic mRNAs
Localization:
Intensity:
Fold change:
Significance:
-
C’ GFP library in SD

cytosol68.32 -
N' NOP1pr-GFP in SD
cytosol154.046 -
N' TEF2pr-mCherry in SD

cytosol109.536 -
N' NATIVEpr-GFP in SD

cytosol56.5914 -
N' TEF2pr-VC and Cyto-VN in SD
cytosol43.8409 -
C’ GFP library in SD+DTT
cytosol54.350.79No -
C’ GFP library in SD+H2O2

punctateN/AN/ANo -
C’ GFP library in Starvation Media

cytosol46.910.68No -
C’ GFP library on the background of Pup2-DaMP

cytosol -
C’ GFP library on the background of CCT mutant

cytosol50.09950.733199No
